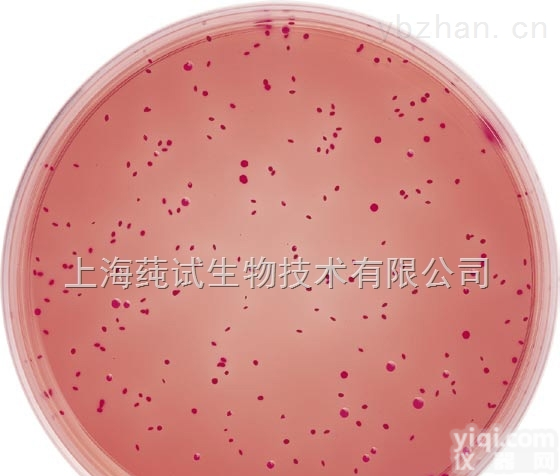
金黄色<em>葡萄球菌</em><em>显色</em><em>培养基</em>培养

产品信息
金黄色葡萄球菌显色培养基 100g(ml)、250g(ml)、500g(ml)等不同规格专业提供
hela细胞培养基|无血清细胞培养基|血清培养基|细胞培养基|免疫细胞培养基|tnm昆虫细胞培养基|cho细胞培养基|巨噬细胞培养基|半固体培养基|固体培养基|液体培养基|进口培养基|国产培养基|原装培养基|ib培养基|ms培养基|pda培养基|dmem培养基|1640培养基|牛肉膏蛋白胨培养基|mrs培养基|培养基价格|培养基批发|培养基专业代理|培养基技术指导
金黄色葡萄球菌显色培养基 公司其它优惠放价产品有:
幼仓鼠肾细胞 BHK细胞 ATCC
ZG仓鼠体细胞 R1610细胞 ATCC
羊膜细胞 WISH细胞 ATCC
牛胚气管 EBTr细胞 ATCC
非洲绿猴肾 VERO细胞 ATCC
猴肾 HepII细胞 ATCC
SV40转化的非洲绿猴肾 COS-7细胞 ATCC
恒河猴肾 LLC-MK2细胞 ATCC
EBV转化的绒猴白细胞 B95-8细胞 ATCC
蓖麻蚕卵细胞 NISE-Sacy-12细胞 ATCC
草鱼吻端细胞 ZC-7901细胞 ATCC
猴脉络膜-视网膜细胞(内皮) RF/6A细胞 ATCC
鼠T淋巴瘤细胞系 YAC-1细胞 ATCC
鼠肾上腺嗜铬细胞瘤细胞系 PC-12细胞 ATCC
BALB/C小鼠肝癌细胞系 H22细胞 ATCC
叙利亚仓鼠肾细胞系 BHK-21细胞 ATCC
ZG仓鼠卵巢细胞系 CHO-K1细胞 ATCC
杂交瘤细胞(B6YH4)支原体阳性 B6YH4细胞 ATCC
猪睾丸细胞系 ST细胞 ATCC
大鼠肾小球系膜细胞 HBZY-1细胞 ATCC
人口腔表皮样癌细胞 KB细胞 ATCC
人口腔上皮癌长春新碱耐药株 KB/V细胞 ATCC
人口腔癌细胞 HB细胞 ATCC
人喉表皮样癌细胞 HEp-2细胞 ATCC
人咽鳞癌细胞 FaDu 细胞 ATCC
人喉癌细胞 M4e细胞 ATCC
人食管癌细胞 EC97076细胞 ATCC
人食管鳞癌 KYSE 150细胞 ATCC
人胃癌细胞系 HS-746T细胞 ATCC
人胃粘膜细胞 GES-1细胞 ATCC
人耐VCR胃腺癌细胞 SGC-7901/VCR细胞 ATCC
专业提供优质细胞培养基等生化产品,公司创新的培养基配方,更有利细胞的繁殖和生长,免费的技术指导和更快捷的免费快递,良好的售后服务,是公司的生存之本,提供更专业,更有权威的培养基配制良方,金黄色葡萄球菌显色培养基 现货大量厂价直销,款到,可实现当天发货,具体发货时间可咨询公司销售人员。